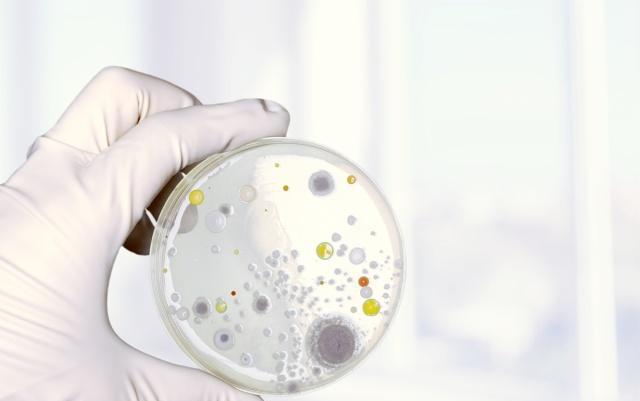
看完你还敢咬指甲吗 不良习惯需警惕

看完你还敢咬指甲吗不良习惯需警惕!
咬指甲的现象在生活中屡见不鲜,无论是孩子还是成年人,很多人都难以抵挡指甲的诱惑。你是否也曾经缠绵悱恻地无聊和紧张中,默默咬着指甲呢?甚至很多明星也曾被捕捉到这个瞬间,长时间咀嚼的指甲在高倍镜头下显得格外不好看,影响了个人形象。面对记者提问,咬指甲的人往往会说“我觉得指甲很好吃”或“咬指甲很舒服”,然后不断地回到这个习惯中。
其实咬指甲不是什么令人自豪的习惯。在别人眼中,这是令人厌恶的行为,不仅会破坏手的外形,而且极不卫生,甚至有可能对你构成伤害。很多人曾经多次想改掉这个习惯,但却始终未能如愿。
一、咬甲癖在医学文献中,有一个专门描述这种习惯的名词:咬甲癖。精神病学家认为这是一种冲动控制问题,属于强迫症的一种。但这只是极端案例,就像撕皮肤和揪头发一样,但很多人都没有达到那种程度——与多数爱咬指甲的人一样,这种行为并没有给我带来严重的不良影响。例如,超过45%的青少年都会咬指甲。青少年在整个人群中的占比或许并不算多,但你不能说有接近一半的青少年都需要接受医学干预。二、为什么有人会喜欢咬指甲?1、咬指甲有遗传因素,一般大人有咬指甲习惯的,孩子也会模仿,所以在日常生活中有爱咬指甲的成人,在孩子面前尽量避免这样的行为。2、在紧张、焦虑、考虑事情的时候会有这种咬指甲的举动,他们通过这种行为来缓解自已在精神上的压力。
三、咬指甲的6种危害1、你的指甲里,藏着各种猥琐的细菌早在2007年,土耳其科学家就给59人做了一个测试,看看咬指甲是否会把手里的细菌输送到嘴里。科学家提取了59人嘴里的唾液。你猜怎么着?在咬指甲的人群中,有76%的人嘴里滋生了各种令人作呕的细菌。而没有咬过指甲的人里,只有26.5%的人才会这样。所以,如果你不想在马桶上了此残生,那就请你赶快把手指从嘴里拔出来!
2、如果你白天咬指甲,晚上就会磨牙你咬指甲说明你很紧张。一旦你白天咬指甲,晚上睡觉时就可能会磨牙。白天咬指甲,晚上磨门牙,白天咬指甲,晚上磨门牙,白天咬指甲,晚上磨门牙……然后你就会愉快地发现,门牙掉了。3、咬指甲会得口腔“性病”!(严肃脸)虽然很罕见,但也不是没有可能。经由一种神秘的姿势,细菌就会从某个羞羞的地方转移到手上,再转移到嘴上……
4、造成指甲畸形咬指甲还可能造成指甲畸形,破坏甲床,引发出血或感染,损伤甲板,使甲板缩短,周边不整齐,甲板板面粗糙,失去原来光泽。
5、影响牙齿美观经常咬指甲会造成牙齿排列不整齐,如牙齿外暴,门牙缺角。看完这些危害,你还敢继续咬指甲么?虽然咬指甲可能是有些人缓解压力的方式,但这是非常不卫生不健康的,改掉咬指甲的坏习惯建议先找出咬指甲的原因,并以嚼口香糖、听音乐等其他方式转移注意力以改善咬指甲的习惯。
盛康配资提示:文章来自网络,不代表本站观点。